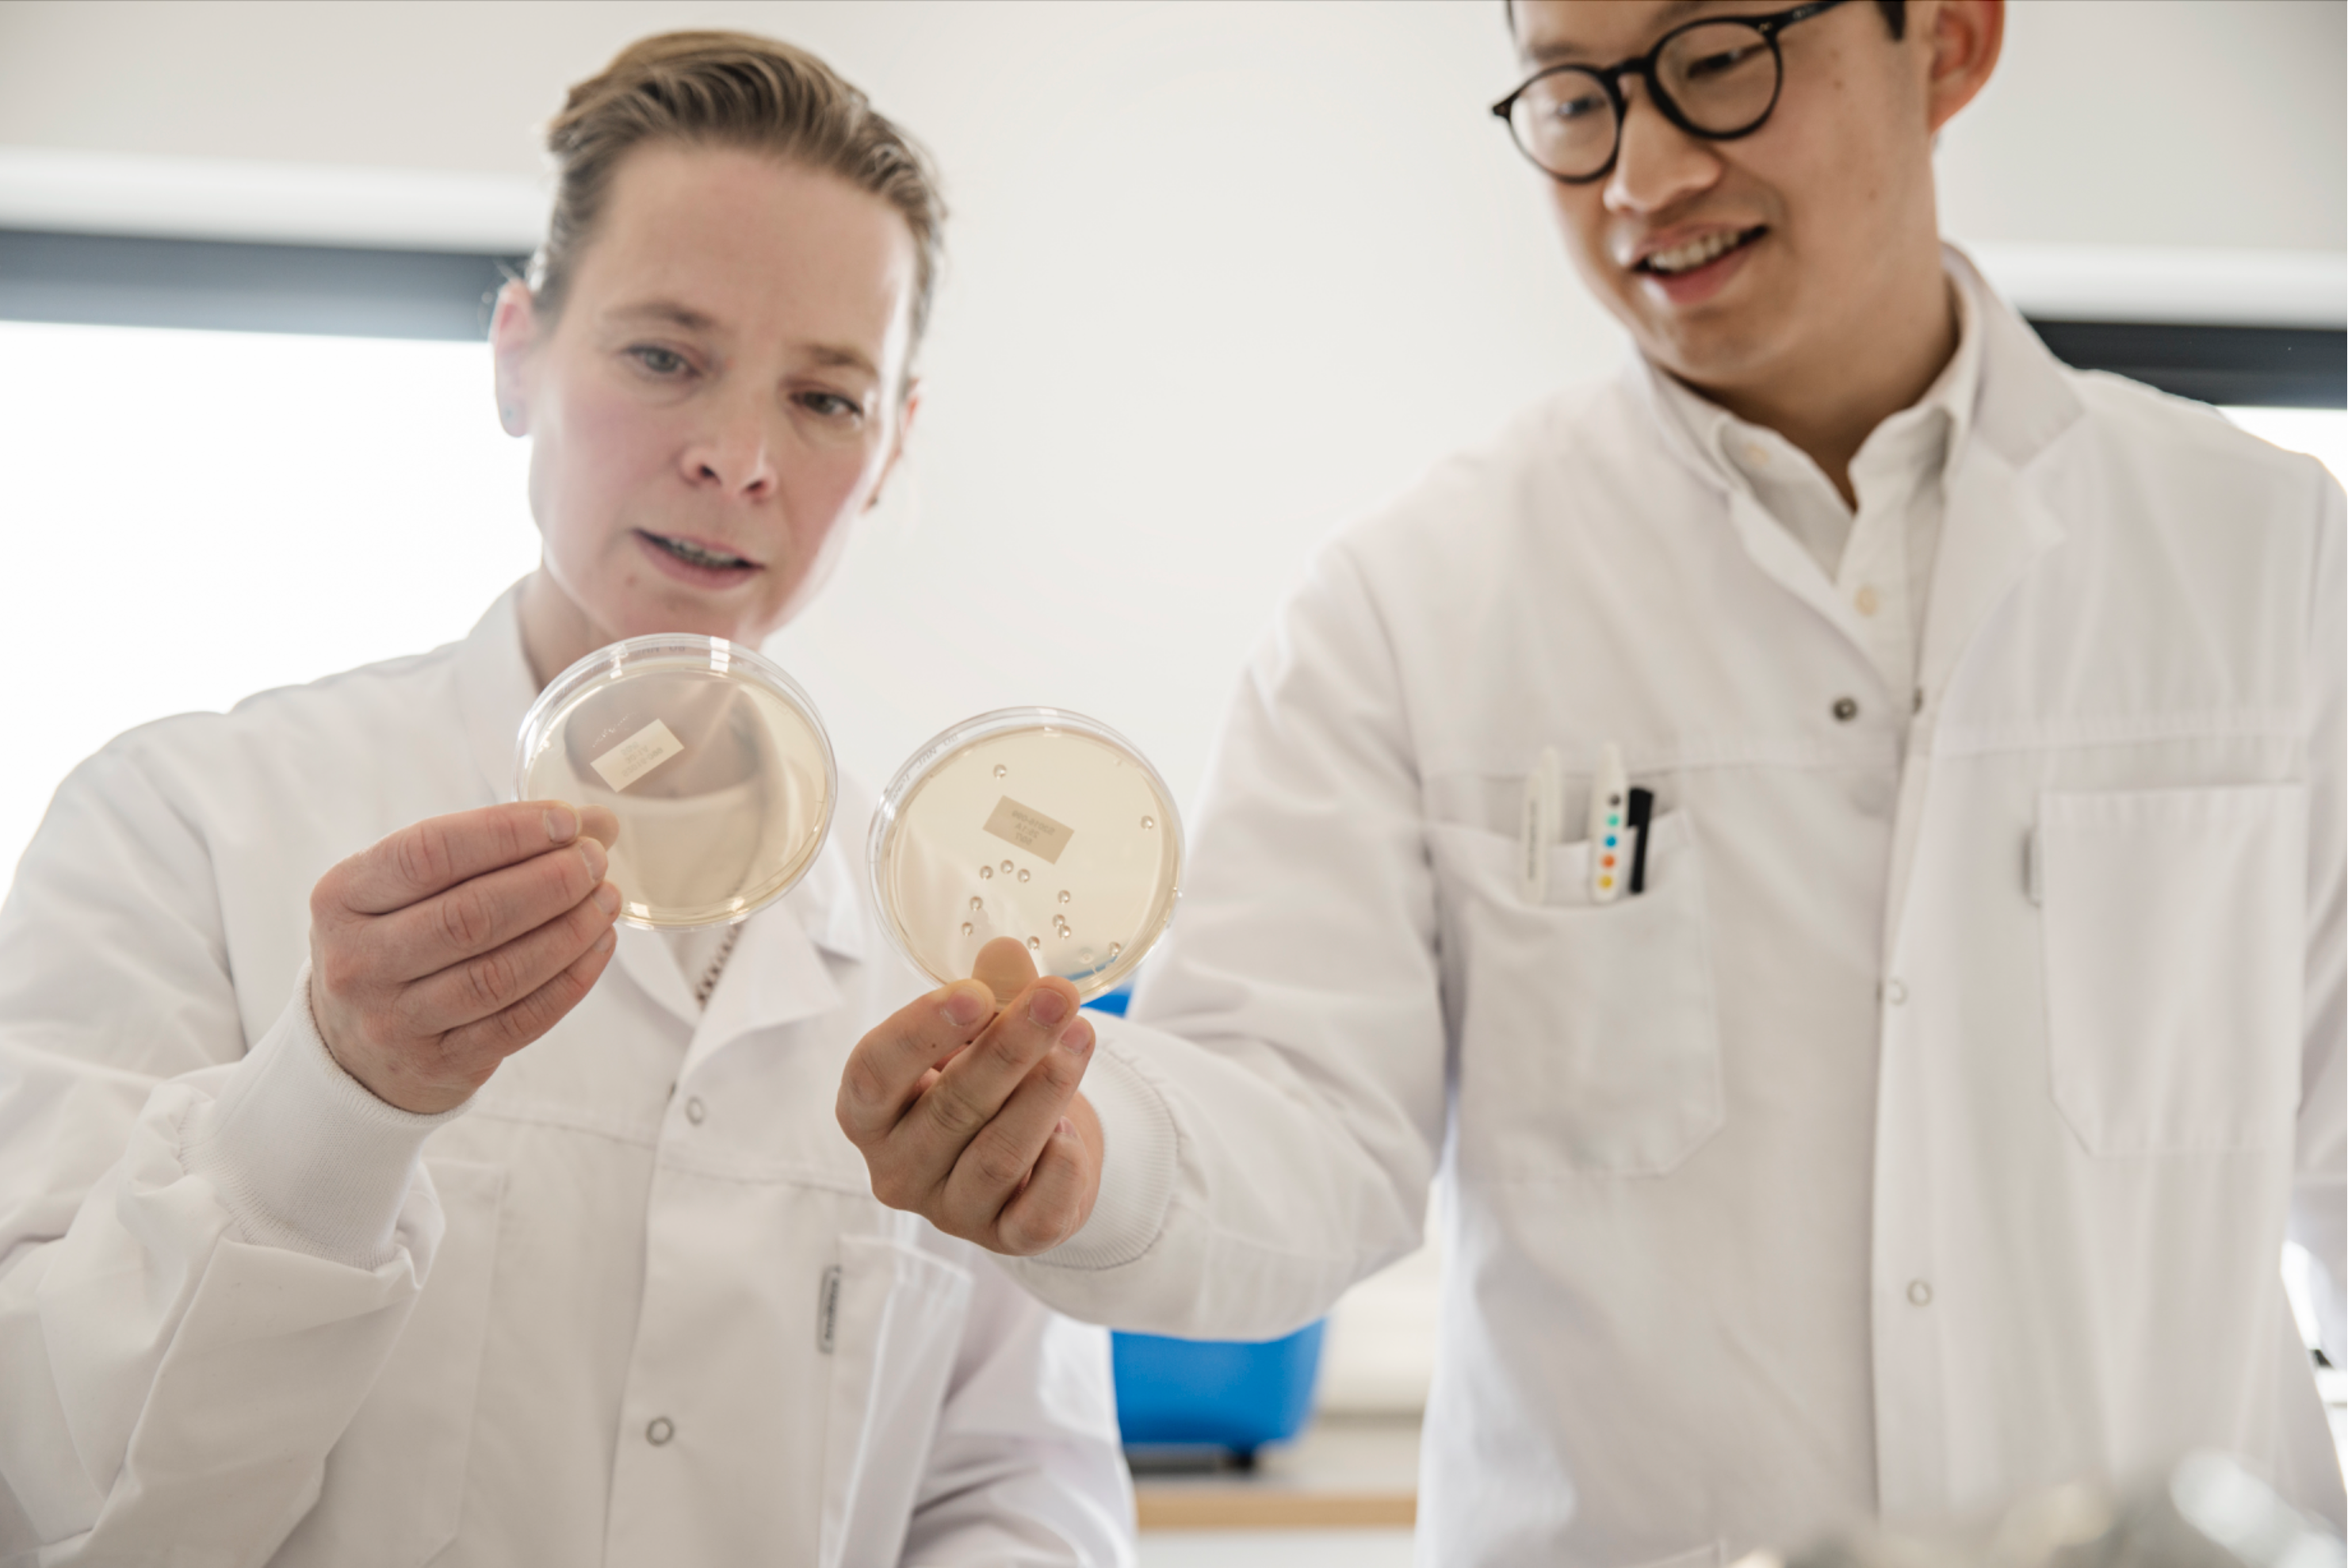

BioGaia® Prodentis® Lozenges - mint flavor
With over 30 years of probiotic research, BioGaia Prodentis is a cutting-edge food supplement expertly crafted to help maintain oral health. Each minty fresh lozenge features two premium, patented bacterial strains that support a balanced oral microbiota. When combined with regular brushing and flossing, Prodentis provides a comprehensive and easy support for oral hygiene.
Why choose this probiotic?
One of the world's most studied probiotic for oral health*
With Isomalt and Xylitol to help maintain strong teeth and enamel**
Supports a balanced oral microbiota
With 30+ years of probiotic expertise
Minty fresh, oral health support made easy
*According to the number of articles, PubMed Apr 2025.
**Consumption of foods containing isomalt and xylitol instead of sugar contributes to the maintenance of tooth mineralisation.
***NO APPROVED THERAPEUTIC CLAIMS
Product information
Bulking agent (isomalt), sweetener (xylitol),L. reuteriDSM 17938 andL. reuteriATCC PTA 5289, peppermint flavouring and menthol flavouring.
*Consumption of foods containing isomalt and xylitol instead of sugar contributes to the maintenance of tooth mineralisation.
Store in a dry place, not above room temperature ( max 25 ℃ / 77℉ ). Keep out reach of children.
For adults and children from 3 years of age. Let the lozenge melt in the mouth. Use daily for oral health. The product can be used during pregnancy and breast-feeding.
Storage:Store in a dry place, not above room temperature (max 25°C). Products should be stored safely out of reach of young children.
Recommended daily dose: 1-2 tablets daily.L. reuteriDSM 17938 andL. reuteriATCC PTA 6475, each tablet contains a minimum of 200 million liveL. reuteri.
Recommended daily dose should not be exceeded. Excessive consumption may produce laxative effects due to the inclusion of sweeteners in the product.
Food supplements should not be used as a substitute for a varied diet.
What is oral health?
Oral health refers to the well-being of your entire mouth, including your teeth, gums, tongue, and other components of the oral cavity such as your oral microbiota.
Maintaining a healthy oral microbiota involves regular dental checkups, proper hygiene, and a healthy diet.
Brushing twice daily, flossing, and regular dental visits are shown to help prevent dental issues.
Oral probiotics are an easy way to support and complement your daily oral care routine.

More than 200,000 hours of probiotic research
People might call us crazy for spending over 30 years researching, analyzing, testing and re-analyzing bacteria strains. But we love science. It's what we do. Behind our products, you will find over 200,000 hours of probiotic research.






